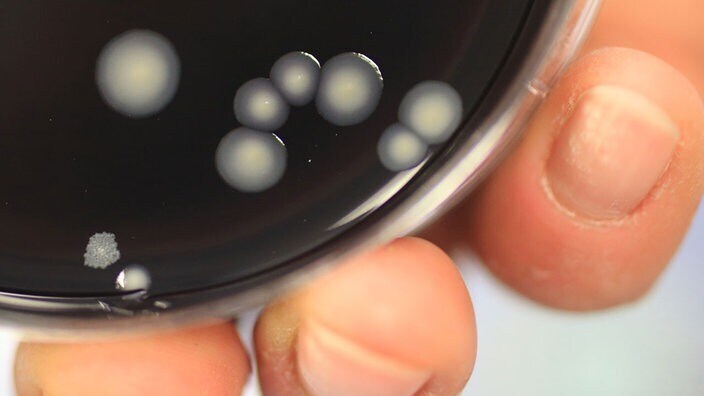
Микроорганизмы: Устойчивые микробы

После открытия антибиотиков бактериальные инфекции, похоже, перестали быть проблемой. Тем не менее, многие бактерии эволюционировали до такой степени, что их больше не беспокоят антибиотики – они стали невосприимчивы к ним.

Антибиотики и формирование устойчивости
Вместо того, чтобы сдерживать размножение микробов с помощью надлежащих мер гигиены, людям довольно щедро давали антибиотики.
Даже сегодня антибиотики используются неправильно, сроки лечения не соблюдаются и назначаются даже против вирусов там, где они вообще не могут действовать.
Не только у людей, но и в животноводстве и даже в растениеводстве антибиотики вводятся в качестве меры предосторожности (профилактики).
Небрежное обращение с антибиотиками приводит к тому, что многие бактерии уже давно привыкли к тем, что когда-то были чудодейственными средствами.
Многие микробы вырабатывают резистентность, что делает антибиотики неэффективными.
Инфекции такими устойчивыми микробами могут затем перерасти в опасные для жизни течения.
Проблема заключается в небрежном обращении с антибиотиками, потому что в ближайшие годы вряд ли можно ожидать открытия новых, пригодных для применения антибиотиков. Драматические смерти, вызванные патогенами с множественной лекарственной устойчивостью, от которых больше не помогают антибиотики, усиливают страх перед эпохой после антибиотиков.

Больничные микробы и гигиена
Микробы с множественной лекарственной устойчивостью встречаются в основном там, где вы действительно надеетесь вылечиться: в больнице.
Именно здесь микробы поражают больных, ослабленных людей, чья иммунная система находится под серьезной нагрузкой.
Поэтому в больнице важно избегать распространения микробов от одного пациента к другому. Для этого необходимо тщательное обучение персонала гигиене.
Политика в отношении борьбы с соответствующими микробами призвана обеспечить большую безопасность в разных странах. Но реализация остается проблематичной. Фактор неправомерного поведения человека остается проблемой.

Лекарство под крышкой
Заклятый враг институтов гигиены - "Золотистый стафилококк".
Бактерия, которая обладает огромной способностью к адаптации и постоянно нападает на больных с множественной лекарственной устойчивостью братьев и сестер.
Поэтому в каждом университете хранятся некоторые антибиотики в секрете – по крайней мере, так и должно быть. "Эти вещества может вводить только главный врач или санитарный врач. Никогда препараты не доставляются бесплатно в отделение или даже пациенту", - говорит профессор Инго Б. Аутенрит из Тюбингенского университета.
Таким образом, его учреждение стремится гарантировать, что в отношении микробов с множественной лекарственной устойчивостью всегда есть козырь в рукаве, к которому бактерии не могут привыкнуть – при условии добросовестного обращения.
Еще одна причина, по которой чудодейственные средства не поступают в свободную продажу: они намного дороже, чем известные продукты.
На борьбу с микробами каждая крупная клиника тратит около 20 процентов своего бюджета.
Если антибиотик вообще перестанет действовать, остается только одно: нужно снова вырастить у пациента нерезистентные микробы.
А именно, они размножаются быстрее, чем устойчивые микробы.
Почему? Устойчивые бактерии встраивают информацию для устойчивости в свою наследственную информацию (ДНК). Это означает, что у вас есть больше информации, которую нужно передать при делении – подобно рюкзаку, который становится все более и более полным.
Иногда вы даже можете найти информацию о 16 резистентностях на кольце ДНК. Это значительно больше наследственной информации, которую необходимо передать.
Быстрорастущий и нерезистентный патоген использует свои боевые вещества для уничтожения микробов с множественной лекарственной устойчивостью. Рискованно при этом: насколько устойчив ослабленный пациент? Стойкие патогены остаются серьезной медицинской проблемой.
Природные боевые вещества
Антибиотики - это природные боевые вещества, которые медицина использует для подавления роста бактерий. Чаще всего они атакуют клеточные стенки бактерий или препятствуют делению бактерий внутри.
Даже в этом случае активный ингредиент распознает своего врага по белкам в клеточной стенке. Клетки животных не имеют клеточных стенок.
Таким образом, антибиотики также не оказывают прямого воздействия на нашу жизненную систему.
Когда-то против бактерий использовались исключительно грибы.
Однако сегодня люди также используют бактерии против бактерий.
Естественное производство антибиотиков заслуживает внимания. Потому что грибы и бактерии выделяют свои токсины наружу.
С другой стороны, хотя животные и высшие растения также производят яды, их вещества остаются в клетках и часто выделяются только при травмах.
Плесень как чудо-оружие
На связь между грибком и бактерией впервые обратил внимание в 1928 году шотландец Александр Флеминг. Результат эксперимента был доставлен ему, так сказать, бесплатно.
Флеминг вернулся из отпуска в свою лабораторию в Лондонском университете.
Он обнаружил, что его бактериальные колонии покрыты плесенью, микробы которой распространяются с воздухом в виде взвешенных частиц.
Флеминг изначально хотел выбросить экспериментальные миски.
Но затем он заметил, что бактерия стафилококка больше не может распространяться там, где выросла плесень. Грибком была кистевидная плесень Penicillium.
Наконец, Флеминг нашел активное вещество против тех бактерий, над которыми он проводил исследования с начала 1920-х годов. Однако профессиональное сообщество не обратило внимания на его публикации. У него самого не было денег.
В то время как его находки хранились в архивах, военные отчаянно искали лекарство от инфекций во время Второй мировой войны, от которых погибло много раненых солдат.
Обладая огромным бюджетом, молодые британские ученые Говард Уолтер Флори и Эрнст Борис Чейн в 1939 году обратились к работам Флеминга – с успехом.
Еще в 1944 году союзные войска имели средство против бактериальных патогенов. Позднее Флеминг получил признание за свои работы в 1945 году вместе с Флори и Чейн: Нобелевская премия по медицине.

Флеминг случайно открыл пенициллин
Через несколько лет после войны в антибиотиках больше не было недостатка. Между тем, они используются против микробов бактериальных инфекций, таких как пневмония, триппер, холера, сифилис, дифтерия, брюшной тиф, туберкулез и болезни Лайма. Возбудитель чумы считается вымершим в Европе.
Стратегия бактериальных патогенов коварна: изначально они только размножаются. Производство яда происходит только после того, как количество микробов превысит определенное количество – без использования девиза: "Вместе мы сильны".
Медицинские работники называют этот период инкубационным периодом.
Только сейчас организм замечает вторжение – и с трудом справляется с множеством очагов.














